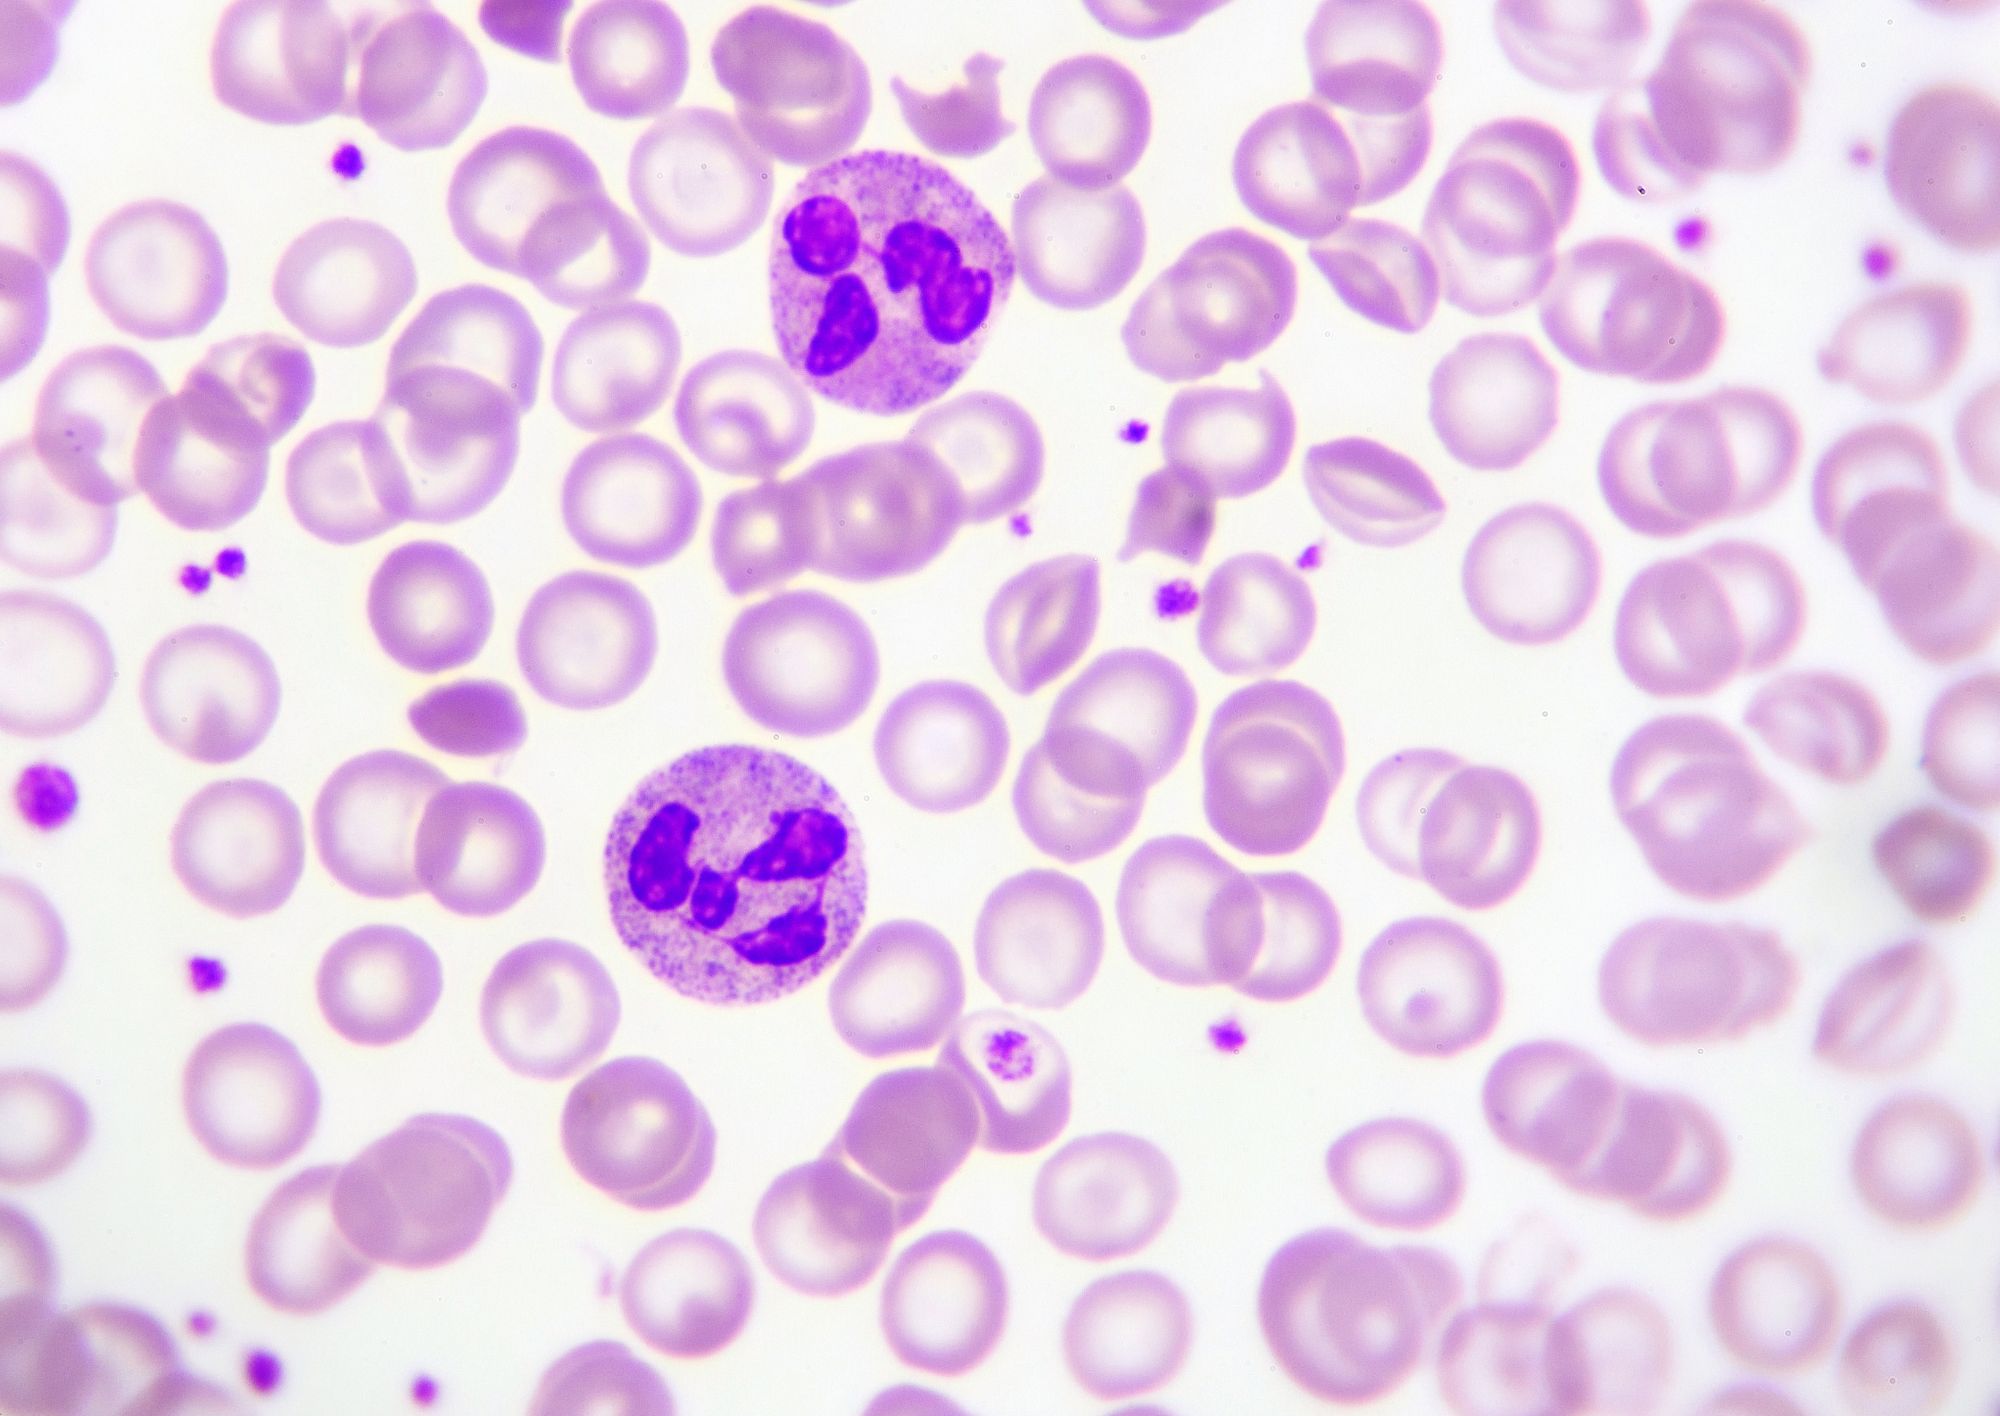

Cosa fa l'ematologo?
L’ematologo è lo specialista che si occupa della diagnosi, prevenzione e cura delle malattie delle cellule del sangue e degli organi che le producono, come midollo osseo, linfonodi e milza. L’ematologia tratta patologie sia benigne sia maligne, che possono manifestarsi con sintomi generici ma rilevanti, come stanchezza, pallore, perdita di peso, febbre, prurito o gonfiore dei linfonodi.
Tra le condizioni più frequenti rientrano l’anemia, dovuta a carenza di ferro o altre cause, l’aumento dei globuli bianchi legato a infezioni o patologie più complesse, e le alterazioni delle piastrine. L’ematologo gestisce anche malattie ematologiche oncologiche come linfoma e mieloma, dove una diagnosi precoce migliora le possibilità di trattamento.
Presso il Sanismart Medical Center, puoi prenotare una visita con un ematologo a Roma che individua rapidamente la causa dei sintomi, propone indagini mirate e definisce il percorso terapeutico più efficace.

Come si svolge una visita ematologica?
Durante una visita ematologica, l’ematologo raccoglie la storia clinica del paziente, indagando sintomi recenti e precedenti malattie. Analizza eventuali esami già disponibili, come l’emocromo, e valuta fattori di rischio personali e familiari. L’esame obiettivo comprende l’osservazione della pelle e delle mucose, la palpazione dei linfonodi e dell’addome per individuare ingrossamenti della milza o del fegato.
Se necessario, lo specialista prescrive ulteriori accertamenti, come analisi del sangue approfondite, test di coagulazione, biopsia linfonodale o aspirato midollare. In caso di sospetto di patologie come linfoma o mieloma, può richiedere esami strumentali come TAC o risonanza magnetica.
La visita ematologica è fondamentale non solo per formulare una diagnosi, ma anche per monitorare l’evoluzione di patologie croniche e adattare il trattamento nel tempo. L’ematologo offre inoltre indicazioni preventive per ridurre i rischi legati a deficit immunitari o disturbi della coagulazione.
Quando andare da un ematologo?
È consigliabile rivolgersi a un ematologo a Roma in presenza di sintomi persistenti come stanchezza inspiegabile, pallore, frequenti episodi di febbre o sudorazione notturna. Alterazioni riscontrate all’emocromo, come anemia, aumento dei globuli bianchi o riduzione delle piastrine, richiedono un approfondimento.
Anche il riscontro di linfonodi ingrossati, petecchie, sanguinamenti frequenti o perdita di peso non motivata deve spingere a una valutazione specialistica. Chi ha familiarità per malattie ematologiche dovrebbe sottoporsi a controlli periodici, soprattutto se compaiono sintomi sospetti.
Una visita tempestiva consente di individuare patologie in fase iniziale, migliorando l’efficacia delle terapie e riducendo il rischio di complicanze. L’ematologo può avvalersi di indagini mirate per definire un piano diagnostico e terapeutico personalizzato.
Prenota una visita con un ematologo a Roma
Affidarsi a un ematologo a Roma del nostro poliambulatorio significa contare su professionisti esperti. Offriamo un approccio completo, che parte dall’ascolto e si sviluppa con una diagnosi accurata, fino alla definizione di un trattamento su misura.
Prenota direttamente online la tua visita oppure contattaci per ricevere tutte le informazioni:
☎️ Telefonicamente allo 06 960 390 24
💬 Su Whatsapp allo (+39) 320 17 52 464
✉️ Via E-mail scrivendo a info@grupposanismart.it
Prenota la tua visita
-
La prescrizione medica è obbligatoria?
No, la prescrizione medica non è obbligatoria per effettuare una visita ematologica.
Cosa devo portare?
Il giorno della visita porta con te:
- Eventuali prescrizioni mediche o referti di visite o esami del sangue precedenti.
- I risultati di eventuali esami diagnostici (es. emocromo, coagulazione, elettroforesi delle proteine).
- Una lista completa dei farmaci attualmente assunti.
-
La prescrizione medica è obbligatoria?
No, la prescrizione medica non è obbligatoria per effettuare una visita ematologica di controllo. Tuttavia, per una visita di controllo bisogna aver precedentemente effettuato una visita ematologica presso il Sanismart Medical Center da non oltre 6 mesi.
Cosa devo portare?
Il giorno della visita porta con te:
- Eventuali prescrizioni mediche, referti di visite o esami del sangue recenti (se disponibili).
- I risultati di eventuali esami diagnostici (es. emocromo, coagulazione, elettroforesi delle proteine).
- Una lista completa dei farmaci attualmente assunti.

